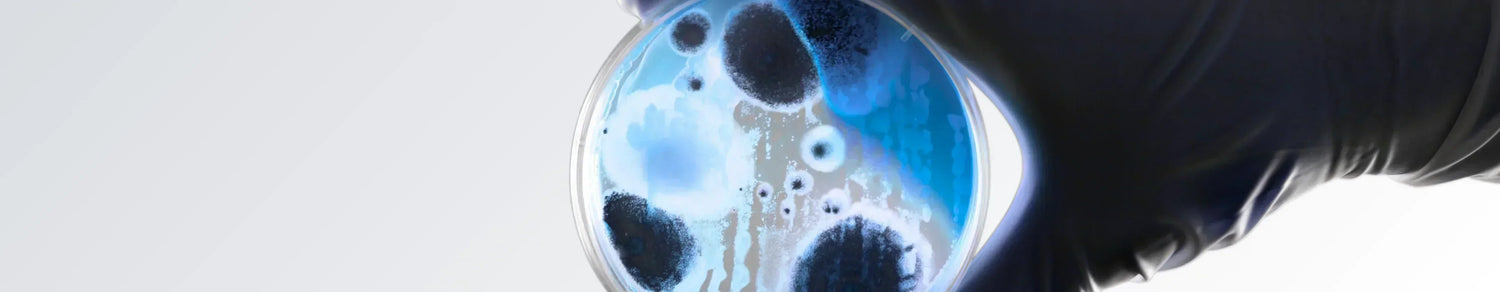
Best Microbiome Testing Kits: Decode Your Gut for Better Health
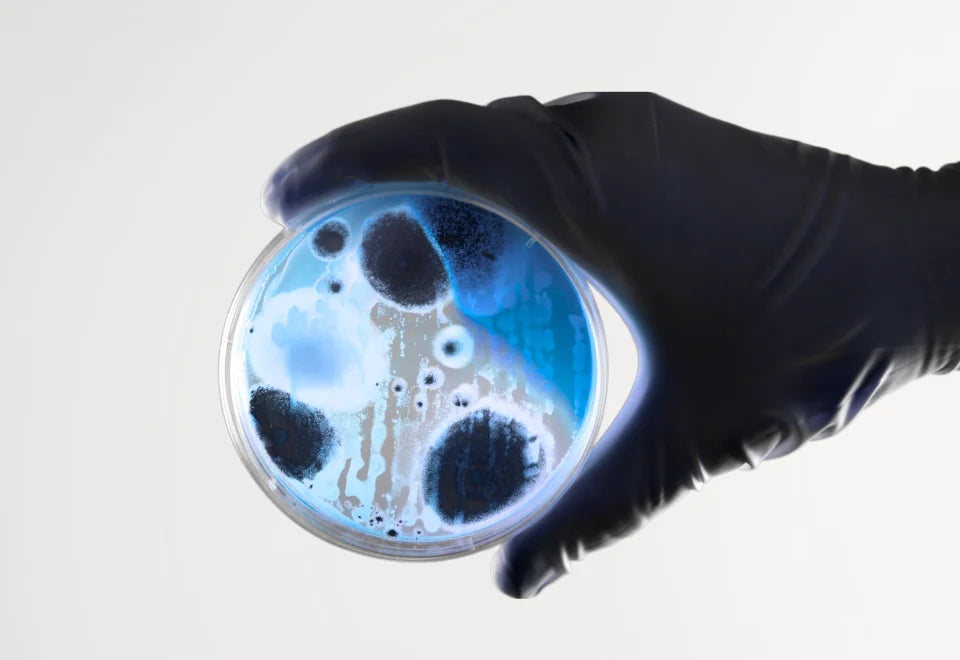

Exploring the world of at-home gut health test kits reveals a new frontier in personalized wellness. These innovative tools analyze the microbes in your digestive system—collectively known as the microbiome—to deliver insights into your gut health, diet, and overall well-being. With options ranging from AI-powered RNA sequencing to whole genome analysis, each kit offers unique features tailored to different health goals and budgets. Whether you're aiming to improve digestion, support longevity, or receive personalized recommendations, there’s a gut health test designed for your journey. Here's a quick overview of five popular options to help you get started.
- Decode Age: Advanced gut analysis with 30+ health markers.
- Viome: Uses RNA sequencing with AI-powered analysis and custom probiotics.
- Ombre (Thryve): Affordable option with 16S rRNA sequencing and food recommendations.
- BIOHM: DNA sequencing- includes bacteria and fungi analysis with live consultations.
- Floré: Whole genome sequencing with custom probiotic formulations.
Quick Comparison
| Kit | Technology | Price | Unique Feature |
|---|---|---|---|
| Viome | RNA sequencing | $169 | AI-driven insights, cancer screening |
| Ombre | 16S rRNA sequencing | $120 | Budget-friendly, food suggestions |
| BIOHM | DNA sequencing | $129 | Includes fungi analysis, consultations |
| Floré | Whole genome | $299 | Custom probiotics, strain-level data |
| Decode Age | Advanced microbiome | Varies | Longevity-focused, provides budget-friendly food suggestions, consultations, blood biomarker integration |
These kits vary in price, technology, and features, helping you choose the one that fits your health goals and budget. Read on to explore each in detail.
Top 5 Best At-Home Gut Health Test Kits for 2024
1. Decode Age
Decode Age stands out in the world of advanced microbiome testing by combining gut health analysis with longevity-focused insights.
This India-based company offers detailed microbiome testing paired with broader health evaluations. Their process delivers a complete analysis, helping users understand their gut health while considering long-term wellness.
| Test Features | Details |
|---|---|
| Analysis Type | Advanced Gut Microbiome Analysis |
| Health Markers | 30+ Gut Health Features |
| Additional Testing | Blood Biomarker Integration |
| Certification | FDA-registered, GMP-certified |
| Price | Variable (Contact Required) |
A Detailed Testing Process
Decode Age combines gut microbiome analysis with over 30 metrics related to longevity. This approach uncovers important details about digestive health and microbial balance, offering insights for precise improvements.
Scientific Standards
Operating from FDA-registered and GMP-certified facilities, Decode Age ensures high-quality testing.
Tailored Health Insights
By integrating microbiome data with blood biomarker analysis (covering 70+ markers), Decode Age provides a complete view of your health, making it easier to address specific health goals.
Availability and Pricing
While Decode Age primarily operates in India, international access may be limited. Pricing details are not fixed and require direct contact for more information.
2. Viome
Viome has carved a niche in microbiome testing by using AI-driven RNA sequencing, known as metatranscriptomics. Unlike standard DNA sequencing, this method focuses on analyzing active microorganisms, giving a detailed view of microbial activity.
The company offers two test options tailored to different health goals and budgets:
| Test Type | Price | Analysis Scope |
|---|---|---|
| Gut Intelligence | $169 | Microbiome composition and gut health markers |
| Health Intelligence | $179 | Includes gut microbiome plus insights on cellular health, immune system, stress response, mitochondrial health, and biological age |
Viome’s proprietary AI analyzes test results against an extensive database of scientific research and customer data. Based on this, it delivers personalized recommendations, including over 200 targeted ingredients for custom probiotics and supplements. Results are processed in-house, ensuring quality and accuracy, with a turnaround time of 2–3 weeks.
Key Benefits
- Detailed microbial analysis
- FDA-approved oral cancer screening
- Custom probiotic and prebiotic formulations
- Quick result processing
- Strong customer support
Potential Downsides
- Higher cost compared to some alternatives
- The depth of information might feel overwhelming to some users
Viome also offers oral and throat cancer screening, making it the only microbiome testing company with FDA-approved cancer detection capabilities. This feature highlights their focus on providing advanced tools for long-term health.
The platform’s insights can be acted upon independently or with a healthcare provider. Recommendations focus on practical dietary adjustments and supplement plans aimed at improving gut health and overall well-being.
3. Ombre (Thryve)
Ombre, previously known as Thryve, is a platform dedicated to gut health. It provides a more affordable and straightforward alternative to Viome's detailed approach, while still delivering useful insights to help improve digestion.
Using 16S rRNA sequencing, Ombre analyzes your gut bacteria. Although this method isn't as detailed as Viome's metatranscriptomics, it still provides practical recommendations at a lower cost.
| Test Package | Price | Features |
|---|---|---|
| Basic Gut Health Test | $99 | Microbiome analysis and dietary recommendations |
| Test + 1x Probiotic | $130.49 | Test kit plus one month of probiotics |
| Test + 3x Probiotic | $188.89 | Test kit plus a three-month probiotic subscription |
The platform excels in turning microbiome data into actionable advice. Users receive tailored recommendations to address issues like bloating, constipation, and other digestive problems.
Key Features
Ombre's test offers a closer look at the bacteria in your gut, highlighting both the good and the bad. Here's what you can expect:
- Detailed breakdown of your gut bacteria
- Custom food recommendations
- Personalized probiotic suggestions
- Insights into immune system health
Processing and Results
While Ombre's processing time is a bit slower compared to some competitors, the company ensures accuracy by using ISO-certified labs. The test kit comes with clear instructions for collecting and sending in your stool sample.
If you're looking for an economical way to start improving your gut health, Ombre offers a personalized option that fits well with a health-conscious lifestyle.
4. BIOHM
BIOHM takes a different approach by examining both bacteria and fungi in your gut. Priced at $129, it uses 16S rRNA sequencing to evaluate gut health. This test goes beyond others by including fungal communities, providing a broader view of your microbiome.
| Test Features | Details |
|---|---|
| Analysis Type | Bacteria and Fungi Analysis |
| Processing Time | 2-3 weeks |
| Report Format | Digital Dashboard |
| Consultation | Live Expert Support |
| Price | $129 (Base Kit) |
Key Features and Analysis
BIOHM’s process is simple, with step-by-step instructions for collecting your sample at home. Once sent to their lab, your microbiome is analyzed, and the results are shared via an easy-to-navigate digital dashboard.
Here’s what their reports include:
- Scores for bacterial and fungal diversity and balance
- Tailored dietary recommendations
- Probiotic suggestions based on your unique results
Expert Support
One standout feature is BIOHM’s live expert consultations. These sessions help you make sense of your results and turn them into actionable lifestyle changes.
Although they don’t offer custom supplement formulations, BIOHM provides pre-formulated probiotics designed to address specific gut issues identified in your test. With its detailed analysis and expert guidance, BIOHM is a great option for anyone looking to explore their gut health without unnecessary complications.
sbb-itb-55c436e
5. Floré
Floré offers a testing kit that uses whole genome sequencing to analyze over 23,000 gut microbes. This includes bacteria, yeast, parasites, fungi, and viruses, all identified at the strain level. The kit is priced at $299 and provides a detailed look into gut health.
| Test Features | Details |
|---|---|
| Analysis Type | Whole Genome Sequencing |
| Detectable Microbes | 23,000+ species |
| Report Format | Digital Dashboard |
| Clinical Markers | Yes |
| Price | $299 (Base Kit) |
Cutting-Edge Testing
Floré's ability to identify microorganisms at the strain level is especially useful for spotting clinical markers related to gut issues like bloating, constipation, and SIBO. These findings can guide targeted solutions for better digestive health.
Tailored Probiotic Recommendations
Once your results are ready, Floré provides customized probiotic suggestions to address your unique gut health concerns. Some of its products even have FDA Breakthrough Device approval, meaning they might qualify for insurance coverage, making this premium service more affordable for some users.
Test Kit Comparison Chart
This chart breaks down the main differences between popular microbiome test kits, making it easier to compare their features, detection capabilities, pricing, and extra perks at a glance.
| Feature | Viome | Ombre | BIOHM | Floré | Decode Age |
|---|---|---|---|---|---|
| Testing Technology | AI-driven metatranscriptomics | 16s rRNA | N/A | N/A | Advanced gut analysis |
| Detects | Bacteria, fungi, archaea, parasites, phages, viruses | Bacteria | Bacteria, fungi | Bacteria, fungi | 30+ gut health features |
| Base Price | $169 | $120 | $129 | $299 | Variable |
| Probiotic Options | Custom-tailored | Pre-formulated | Pre-formulated | Custom probiotic formulations | Not included |
| Additional Features | Cancer screening, AI insights | Food recommendations | Live consultation | Custom probiotic formulations | Blood biomarker integration |
| Lab Certification | FDA Breakthrough Device designation | N/A | N/A | N/A | FDA-registered, GMP certified |
Key Differentiators
Here’s what makes each kit stand out:
- Decode Age: Goes beyond gut microbiome testing by integrating blood biomarker analysis for a broader health perspective.
- Viome: Combines FDA-approved cancer screening with advanced AI-powered analysis, offering a wide detection range.
- Ombre: The most budget-friendly option at $120, focusing on bacterial detection and personalized food recommendations.
- BIOHM: Includes fungi detection and provides live consultation for added support.
- Floré: Specializes in creating custom probiotic formulations tailored to your results.
Testing Accuracy
Accuracy matters, and methods like Viome's metatranscriptomics and Decode Age's FDA-registered processes ensure reliable results. Each kit has its own strengths in terms of detection range, personalization, and user support.
Use this comparison to decide which kit fits your health needs and budget. Up next, we’ll dive into how to choose the best microbiome test for your goals.
How to Choose Your Microbiome Test
Here's a guide to help you pick the microbiome test that fits your needs and budget.
Match the Testing Method to Your Goals
What kind of analysis are you looking for? If you want an in-depth look at your gut's ecosystem, go for tests using advanced methods that provide detailed microorganism data. On the other hand, if you're just looking for a basic overview at a lower price point, simpler sequencing methods might be enough.
Align with Your Health Goals
Different tests target different objectives. Here's a quick breakdown:
- General Gut Health: Basic insights with food suggestions.
- Detailed Mapping: Comprehensive microbiome analysis.
- Personalized Insights: Advanced features tailored to your health.
- Broader Health View: Integrated testing for a full-picture approach.
Check Turnaround Time and Support
Processing times and support options vary. For instance, Viome and Decode Age delivers results in 3–4 weeks, while other tests may take up to 6 weeks. Some companies also offer live consultations or dietary advice, which can be a helpful bonus.
Look for Scientific Backing
Choose tests with strong scientific credentials. Keep an eye out for:
- FDA registration and GMP certification.
- Peer-reviewed research backing their methods.
- Transparent processes and rigorous quality checks.
These factors ensure you're getting reliable and accurate results.
Factor in Your Budget
| Price Range | What You Get | Who It's For |
|---|---|---|
| $120–150 | Basic bacterial profiling | Those on a budget needing simple insights |
| $150–200 | Comprehensive analysis | People wanting detailed gut health data |
| $200–300 | Advanced testing with personalized recommendations | Anyone seeking tailored health solutions |
Some companies also offer subscription plans, which can include regular testing and probiotic subscriptions for ongoing gut health management.
Think About Healthcare Integration
Finally, consider how the test results fit into your overall health plan. Look for tests that provide clear, actionable data. Detailed reports can be especially helpful when working with your healthcare provider to create a personalized treatment plan.
FAQs
What is a microbiome test, and how does it work?
A microbiome test analyzes the microbes, such as bacteria, fungi, and other microorganisms, in your digestive system. It typically involves collecting a stool sample at home, which is then sent to a lab for analysis. The test results provide insights into your gut health and help identify imbalances or areas for improvement.
What are the main types of microbiome tests?
Microbiome tests vary based on the technology used:
- 16S rRNA Sequencing: Identifies bacterial species by analyzing a specific region of their DNA.
- RNA Sequencing (Metatranscriptomics): Analyzes active microorganisms in the gut to give a deeper understanding of microbial activity.
- DNA Sequencing/Whole Genome Sequencing: Provides a more comprehensive analysis, identifying a wide range of microbes at the strain level.
What do I get from a microbiome test?
Test results typically provide a breakdown of your gut microbes, including bacteria, fungi, and other microorganisms. You may receive insights on:
- Microbial diversity and balance
- Personalized dietary and supplement recommendations
- Gut health markers (e.g., inflammation, digestion efficiency)
- Probiotic suggestions tailored to your unique gut composition
Are the results of microbiome tests accurate?
Yes, most of the microbiome tests mentioned (e.g., Viome, Decode Age, Floré) use scientifically validated methods, such as FDA-registered processes or GMP-certified labs, to ensure accurate results. They also use peer-reviewed research to back their findings.

Leave a comment
All comments are moderated before being published.
This site is protected by hCaptcha and the hCaptcha Privacy Policy and Terms of Service apply.